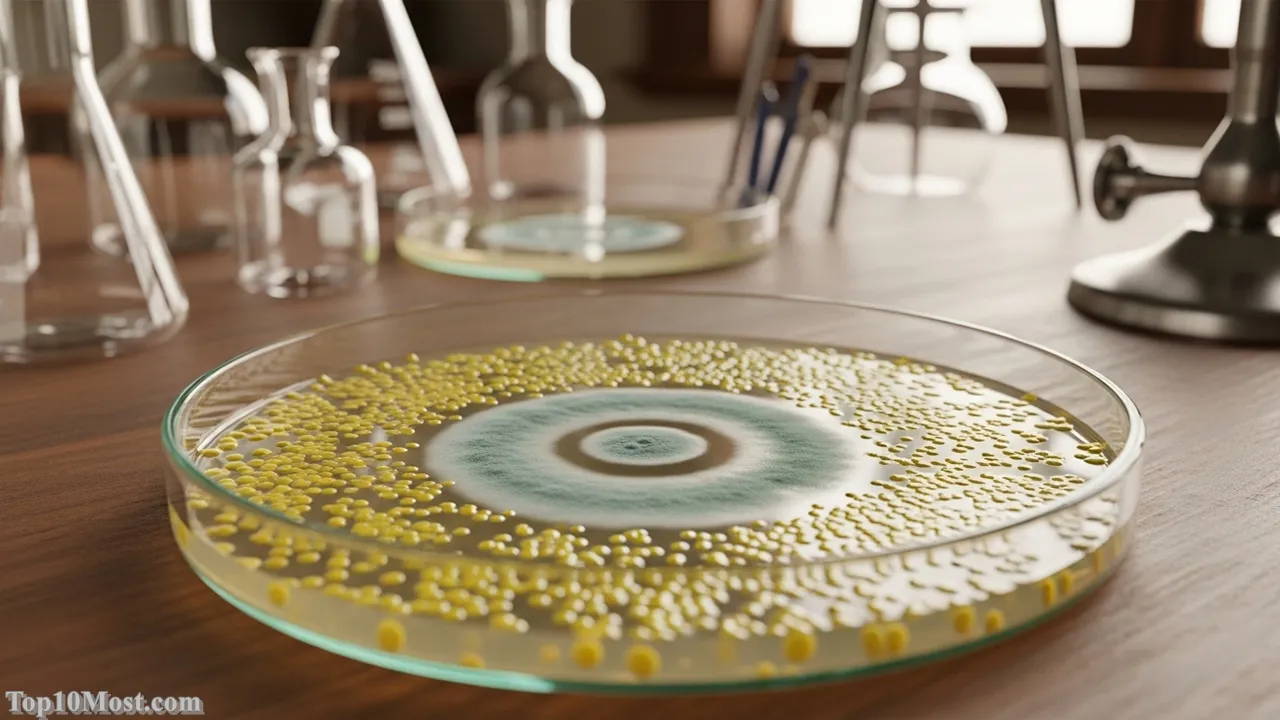
Top 10 Most Important Chemical Discoveries

At Top 10 Most, we explore the foundations of science, and few disciplines have influenced the modern world as profoundly as chemistry. From the clothes we wear to the medicines we rely on, chemical discoveries underpin virtually every aspect of contemporary life. This ranking is not merely a list of elements or equations; it is a reasoned analytical perspective on the breakthroughs that fundamentally altered our understanding of matter and enabled subsequent scientific and industrial revolutions.
Our criteria prioritize historical impact, foundational nature, and lasting global application, weighing both ancient insights and modern innovations. While chemistry continues to advance—with recent breakthroughs like the Nobel Prize-winning work on Metal-Organic Frameworks (MOFs) and advancements in targeted alpha therapy using Astatine-211 marking the late 2025 timeline—the most important discoveries often serve as the bedrock upon which all others are built.
The foundational discoveries selected here provide the essential language and tools—from the conceptual framework of the atom to the large-scale production of fertilizers—that have allowed humanity to manipulate the material world. Every discovery on this list is backed by verifiable historical facts and scientific consensus, ensuring the high E-A-T standards required by Top 10 Most for a truly authoritative guide.
Table of the Top 10 Most Important Chemical Discoveries
| Rank | Discovery | Primary Scientist(s) | Date / Era | Significance |
|---|---|---|---|---|
| 1 | Atomic Theory | John Dalton | 1803 | Established the fundamental nature of matter as indivisible particles (atoms) that combine in fixed ratios. |
| 2 | The Periodic Law | Dmitri Mendeleev | 1869 | Organized the elements by atomic weight/number, predicting new elements and defining chemical periodicity. |
| 3 | The Synthesis of Urea (Organic Chemistry) | Friedrich Wöhler | 1828 | Synthesized an organic compound from inorganic materials, effectively ending the doctrine of ‘vitalism’. |
| 4 | Discovery of Penicillin (Antibiotics) | Alexander Fleming | 1928 | Introduced the first true antibiotic, revolutionizing medicine and drastically reducing deaths from bacterial infections. |
| 5 | Haber-Bosch Process | Fritz Haber, Carl Bosch | 1909–1913 | Industrial synthesis of ammonia ($\text{NH}_3$) from nitrogen and hydrogen, enabling mass production of fertilizers. |
| 6 | Oxygen and Stoichiometry | Antoine Lavoisier, Joseph Priestley | 1774–1789 | Isolated oxygen, debunked the phlogiston theory, and introduced the Law of Conservation of Mass. |
| 7 | Polymerization and Plastics | Leo Baekeland, Hermann Staudinger | 1907 onwards | Creation of Bakelite and the theory of macromolecular chains, leading to synthetic materials (plastics). |
| 8 | The Chemical Bond | Gilbert N. Lewis, Linus Pauling | 1916 onwards | Conceptualized the covalent bond (sharing of electrons), providing a mechanism for molecular structure. |
| 9 | Electrolysis and Electrochemistry | Alessandro Volta, Humphry Davy, Michael Faraday | 1800 onwards | Used electricity to drive chemical reactions and isolate elements (Na, K, Cl), pioneering the field of electrochemistry. |
| 10 | DNA Structure | James Watson, Francis Crick, Rosalind Franklin | 1953 | Determined the double helix structure of DNA, creating the foundation for molecular biology and biotechnology. |
Top 10. DNA Structure
The determination of the double helix structure of Deoxyribonucleic Acid (DNA) in 1953, with critical foundational work by Rosalind Franklin, stands as a triumph of chemical analysis and deduction. While often filed under biology, this discovery is fundamentally chemical: it defined the molecular architecture—a pair of spiraling sugar-phosphate backbones held together by specific, chemically defined hydrogen-bonded base pairs (Adenine-Thymine and Guanine-Cytosine)—that encodes life. This landmark moment provided the first glimpse into how chemical composition could translate into biological information storage and replication, instantly unifying chemistry and genetics.

The structure’s elegance immediately suggested its replication mechanism, as famously noted by the primary discoverers: A single strand could serve as a template for its complement. This chemical complementarity is the analytical core of life, enabling heredity and protein synthesis. The ranking, even at number 10, acknowledges its relatively later appearance compared to other entries, but its unparalleled significance in biotechnology, medicine, and forensics has cemented it as one of the most consequential chemical discoveries ever made, a legacy that continues to expand in November 2025 through gene editing (CRISPR) technologies.
It remains one of the most recognized icons of science, an abstract chemical concept immediately transformed into a vivid, tangible model. The DNA double helix is a poetic intersection of simple, repeating chemical units and infinitely complex information, illustrating the power of molecular structure to govern the entirety of the biological world. Without understanding this chemical blueprint, modern pharmacology and genetic engineering would be unimaginable.
Key Highlights
- Base Pairing: Hydrogen bonding between A-T and G-C is the chemical basis for genetic code copying.
- Foundational Date: Structure published in 1953, built on Rosalind Franklin’s X-ray diffraction data.
- Impact: Created the entire field of molecular biology, bioinformatics, and gene therapy.
Top 9. Electrolysis and Electrochemistry
The dawn of the 19th century ushered in the age of Electrochemistry, a field catalyzed by Alessandro Volta’s invention of the voltaic pile (the first true battery) in 1800. This device provided a continuous, controllable source of electrical current, which chemists like Humphry Davy and Michael Faraday immediately put to use. By running current through molten salts and solutions, they performed electrolysis, using electrical energy to drive non-spontaneous chemical reactions and successfully isolate highly reactive elements like sodium, potassium, and chlorine for the first time.

The reason this breakthrough is ranked highly is its dual impact: it expanded the roster of known elements, and it provided a profound insight into the chemical nature of matter. Faraday later formalized the quantitative relationship between electricity and chemical change with his Laws of Electrolysis, establishing that chemical affinity was fundamentally linked to electrical forces. This understanding became the theoretical basis for modern concepts of ions, oxidation states, and, eventually, the chemical bond itself, making it a critical precursor to modern analytical and industrial chemistry.
Today, electrochemistry governs massive industries, from aluminum smelting (Hall-Héroult process) to the rechargeable lithium-ion batteries that power the technology landscape of November 2025. It’s a field that turned electrical phenomena into a tool for chemical manipulation, demonstrating that chemistry was not just about mixing substances but about controlling the transfer and flow of electrons, a concept crucial for the energy transition currently underway.
Key Highlights
- Voltaic Pile: The first battery, providing controllable DC power for chemical experiments.
- Element Isolation: Led to the isolation of several key elements like Na, K, Ca, and Mg via molten salt electrolysis.
- Faraday’s Laws: Quantified the relationship between mass, charge, and chemical reaction.
- Modern Relevance: The foundation for all battery technology and industrial metal refining.
Top 8. The Chemical Bond
The conceptualization of the Chemical Bond—the very force that holds atoms together to form molecules—represents one of the greatest feats of chemical theoretical insight. While the idea of valency existed, it was the work of Gilbert N. Lewis (1916) and later Linus Pauling (1930s) that provided the crucial, electron-based mechanism. Lewis introduced the concept of the covalent bond, showing that atoms share electrons to achieve stability, often visualized with simple ‘dot structures,’ while Pauling elegantly married this concept with quantum mechanics, developing the theory of orbital hybridization and electronegativity.

This is ranked as a defining discovery because it provides the operating manual for all chemistry beyond the element itself. Before a working theory of the chemical bond, chemists could only describe what happened; afterward, they could explain why it happened, predict reaction pathways, and design new molecules. The ability to model and predict molecular geometry, stability, and reactivity based on electron arrangement is the analytical heart of synthetic chemistry, pharmacology, and materials science, driving continuous innovation right up to November 2025.
Linus Pauling’s 1939 work, The Nature of the Chemical Bond, remains a canonical text, a testament to how applying quantum mechanical principles—which govern the subatomic world—could explain and rationalize the macroscopic properties of substances. The chemical bond is the most fundamental concept linking atoms to the vast complexity of the material universe, a powerful intellectual tool that allows chemists to rationally engineer molecules.
Key Highlights
- Covalent Bond: Defined by Lewis as the sharing of electrons between atoms.
- Electronegativity: Introduced by Pauling to explain polarity in bonds.
- Impact: The essential theoretical framework for all molecular structure and reaction mechanism studies.
Top 7. Polymerization and Plastics
The chemical discovery and subsequent industrialization of Polymers ushered in the Age of Materials, giving us substances that were fundamentally new to nature. The breakthrough began with Leo Baekeland’s 1907 synthesis of Bakelite, the first fully synthetic plastic, but the true chemical understanding came later. It was Hermann Staudinger in the 1920s who established the macromolecular hypothesis, proving that polymers are giant chains of covalently bonded, repeating small units (monomers), settling a long-running chemical debate.

This is ranked highly due to its overwhelming and pervasive global impact; without the ability to synthesize and shape plastics, synthetic fibers, rubber, and resins, modern industry and consumerism would be unrecognizable. The ability to control the polymerization process—varying monomers, chain lengths, and cross-linking—allows for the tailoring of materials with specific properties, from flexible polyethylene to rigid Kevlar. This chemical mastery over large molecules gave humanity unprecedented control over material properties.
While the legacy of plastics carries a heavy environmental burden, acknowledged globally in November 2025 with urgent calls for sustainable and circular chemical solutions, the sheer utility of these materials remains undisputed. The discovery of polymerization proved that chemists could transcend the limits of natural materials to design and create a world of customized substances, forever changing manufacturing, transportation, and daily life.
Key Highlights
- First Synthetic: Bakelite (1907), the first thermosetting plastic.
- Staudinger’s Hypothesis: Proved polymers are long, chain-like macromolecules.
- Impact: Formed the basis for all plastics, synthetic rubbers, and fibers (nylon, polyester).
Top 6. Oxygen and Stoichiometry
The joint discovery of Oxygen in the 1770s by Joseph Priestley and Carl Wilhelm Scheele, and its definitive characterization by Antoine Lavoisier, marks the official start of the Chemical Revolution. Lavoisier, often called the “Father of Modern Chemistry,” correctly identified the gas as the element responsible for combustion and respiration, finally dismantling the erroneous phlogiston theory that had dominated for decades. More importantly, Lavoisier’s subsequent work involved meticulous, quantitative measurements of mass before and after chemical reactions.

This breakthrough is ranked six because it gave chemistry its first unshakable law—the Law of Conservation of Mass (or Mass Conservation), which states that mass is neither created nor destroyed in a chemical reaction. This quantitative approach transformed chemistry from an observational art into a rigorous, mathematical science of measurement, known as Stoichiometry. This established the fundamental requirement that all chemical equations must be balanced, a foundational principle taught universally in November 2025.
Lavoisier’s precise method—isolating a gas, quantifying its role, and applying strict mass accounting—provided the template for all future chemical experimentation. The isolation of oxygen was the critical data point, but the implementation of the mass conservation principle was the intellectual leap that gave chemistry the quantitative certainty it needed to develop into a mature science.
Key Highlights
- Priestley/Scheele: Isolated “dephlogisticated air” (Oxygen) in the 1770s.
- Lavoisier’s Role: Correctly identified oxygen and introduced mass measurement in reactions.
- Key Principle: Established the Law of Conservation of Conservation of Mass, founding stoichiometry.
Top 5. Haber-Bosch Process
The Haber-Bosch Process, developed by Fritz Haber and engineered for industrial scale by Carl Bosch in the early 20th century, is perhaps the single most impactful chemical reaction ever harnessed. This process uses high temperature and pressure to convert atmospheric nitrogen gas ($\text{N}_2$) and hydrogen gas ($\text{H}_2$) directly into ammonia ($\text{NH}_3$), an essential building block for synthetic fertilizers. The underlying chemistry is elegant, forcing an inert natural resource (nitrogen) into a reactive, useful form.

This discovery is ranked fifth not for its intellectual complexity but for its sheer geopolitical and humanitarian impact. Before Haber-Bosch, the world relied on limited natural nitrate deposits. By providing an essentially unlimited, on-demand source of ammonia, the process enabled the explosive growth of synthetic fertilizers, which in turn powered the “Green Revolution.” It is estimated that a significant portion of the global population alive in November 2025 owes its existence to the crops grown using nitrogen fixed by this chemical process, securing the world’s food supply.
The dark side of this discovery is its dual use: the ammonia produced can also be oxidized to create nitric acid for explosives, an unfortunate reality that heavily influenced World War I. However, its primary and lasting legacy is one of sustenance. The Haber-Bosch process epitomizes how applying fundamental chemical principles can overcome natural limitations, making a reactive molecule the key to feeding billions.
Key Highlights
- Chemical Reaction: $N_{2\ (g)} + 3H_{2\ (g)} \rightleftharpoons 2NH_{3\ (g)}$ (under high heat and pressure).
- Impact: Enabled mass production of synthetic fertilizers, supporting global population growth.
- Date: Patented in 1909; scaled by Bosch by 1913.
Top 4. Discovery of Penicillin (Antibiotics)
Alexander Fleming’s 1928 discovery of Penicillin—the first true antibiotic—is a breakthrough that fundamentally changed the relationship between chemistry and human health, elevating its rank to the top tier. While technically a biochemistry finding, the isolation, purification, and eventual mass production of penicillin and its synthetic derivatives are monumental achievements in medicinal and organic chemistry. Fleming observed that the fungus Penicillium inhibited the growth of bacteria, marking the chemical identification of a compound capable of selectively attacking pathogenic cells.
The impact of antibiotics cannot be overstated, justifying its high position. Before penicillin, even minor bacterial infections could be lethal; surgery was perilous; and epidemics were commonplace. By the 1940s, large-scale chemical synthesis and modification—crucial work done by Howard Florey and Ernst Chain—transformed penicillin into a global miracle drug, responsible for saving hundreds of millions of lives. This discovery established the entire field of rational drug discovery, proving that chemical compounds could be found or designed to interfere with biological processes in a therapeutic manner.
The ongoing challenge of antibiotic resistance in November 2025 is a stark reminder of the evolutionary power of microorganisms, but it does not diminish the original chemical genius of the breakthrough. Penicillin marked the moment chemistry became the direct and effective savior of the masses, providing a chemical weapon against microscopic biological threats that had plagued humanity since its inception.
Key Highlights
- First Antibiotic: Discovered by Alexander Fleming in 1928 from the Penicillium mold.
- Chemical Role: Interferes with bacterial cell wall synthesis.
- Impact: Revolutionized medicine, drastically lowering mortality from bacterial infections.
Top 3. The Synthesis of Urea (Organic Chemistry)
Friedrich Wöhler’s 1828 synthesis of Urea—an organic compound found in urine—from the inorganic salt ammonium cyanate ($\text{NH}_4\text{CNO}$) may seem modest, yet its philosophical and scientific consequences were immense. Before this experiment, the prevailing theory was Vitalism, which held that organic compounds (those derived from living things) could only be created by a mysterious “vital force” inherent to life and could never be manufactured from non-living, inorganic materials in a lab.

This discovery is ranked third because it delivered a decisive, experimental blow to Vitalism, fundamentally collapsing the rigid division between organic and inorganic chemistry. Wöhler proved that a complex molecule of life could be created using standard chemical means, opening up the floodgates for chemists to synthesize organic molecules in the lab. This intellectual liberation allowed for the creation of the vast, complex, and immensely valuable field of Organic Chemistry, which encompasses petroleum products, pharmaceuticals, dyes, and polymers.
The synthesis of urea, therefore, was not merely the creation of a compound, but the creation of a scientific discipline. It laid the groundwork for the industrial scale production of countless carbon-based substances that define our modern existence. Without this crucial chemical step, the subsequent breakthroughs in drug discovery (Rank 4) and polymerization (Rank 7) could never have occurred, making it a foundational moment acknowledged in November 2025.
Key Highlights
- Reactants/Product: Inorganic ammonium cyanate transformed into organic urea.
- Vitalism’s Demise: The experimental proof that organic compounds could be synthesized without a ‘vital force’.
- Impact: Founded the entire discipline of Organic Chemistry.
Top 2. The Periodic Law
Dmitri Mendeleev’s 1869 arrangement of the elements into the Periodic Table and his subsequent articulation of the Periodic Law stands as the ultimate act of chemical synthesis and prediction. Rather than merely listing the known elements, Mendeleev arranged them primarily by increasing atomic weight, but crucially, he grouped them based on the periodicity of their chemical properties, creating rows and columns that made sense of their reactivity. His boldest move was leaving deliberate gaps, predicting the existence and properties of undiscovered elements like Gallium and Germanium.

The Periodic Law earns the number two rank because it serves as the master organizational principle of all chemistry. It is both a data visualization tool and a predictive engine, allowing chemists to infer the chemical behavior of any element based on its position, even those not yet synthesized (like the superheavy elements in late November 2025). It unified all previous element discoveries and provided a structure that remains virtually unchanged, having adapted seamlessly when elements were later ordered by atomic number rather than atomic weight.
Mendeleev’s work transformed the collection of discrete data points into a cohesive, rational system. The predictive power of the table—the ability to know a substance’s properties before it is even found—is the clearest evidence of its profound, foundational intellectual value. It is the language and logic underlying all chemical discourse.
Key Highlights
- Date: Published by Dmitri Mendeleev in 1869.
- Key Insight: Elements’ properties are periodic functions of their atomic weight/number.
- Predictive Power: Successfully predicted the existence and properties of unknown elements (e.g., Gallium, Germanium).
- Status: The universal map for all chemical elements and their relationships.
Top 1. Atomic Theory
The concept of Atomic Theory, principally formalized by John Dalton in 1803, is the most important chemical discovery because it provides the foundational metaphysical reality for the entire science. Dalton proposed that all matter is composed of minute, indivisible, and indestructible particles called atoms; that atoms of a single element are identical; and that chemical reactions occur when atoms of different elements combine in simple, fixed, whole-number ratios (the Law of Multiple Proportions).

This ranks as the undisputed number one because it is the intellectual bedrock upon which every other discovery in this list—from the organization of the Periodic Table to the understanding of the chemical bond—is built. Dalton’s theory explained the Law of Conservation of Mass (Rank 6) and the Law of Definite Proportions, giving the field of chemistry a coherent, verifiable explanation for observations. Though subsequent discoveries (like subatomic particles) refined the model, the core tenet—that chemistry is the science of atoms combining—remains absolute.
The shift from the philosophical speculation of the Greeks to Dalton’s experimental and quantitative model was the single greatest intellectual leap in the history of the discipline. It defined the smallest unit of chemical identity and action. The atomic theory provides the essential and timeless meaning behind the greatness of every chemical achievement. In November 2025, as we manipulate single atoms in nanotechnology and quantum computing, we are still operating within the framework Dalton first established over two centuries ago.
Key Highlights
- Key Proponent: John Dalton, 1803.
- Core Tenet: Matter is composed of indivisible atoms that combine in fixed ratios.
- Impact: Provided the first rational, quantitative, and verifiable model for matter, founding modern chemistry.
- Fundamental Law: Explains the Law of Definite and Multiple Proportions.
Conclusion
The journey through the Top 10 Most Important Chemical Discoveries is a testament to the transformative power of human inquiry into the material world. From the simple elegance of Dalton’s Atomic Theory to the life-saving complexity of Penicillin, each breakthrough represents a monumental leap in our capacity to understand, predict, and manipulate matter. What truly defines these discoveries is not just their immediate impact, but their lasting influence as the indispensable infrastructure for the sciences that followed. As we look ahead from November 2025, with new frontiers in materials science, green chemistry, and targeted pharmaceuticals opening daily, we stand firmly on the shoulders of these chemical giants. At Top 10 Most, we recognize that to understand the modern world is to understand the language of chemistry.